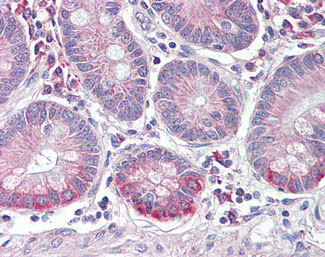
SLC10A2 Antibody in Immunohistochemistry (Paraffin) (IHC (P))

Search
Invitrogen
SLC10A2 Polyclonal Antibody
{{$productOrderCtrl.translations['antibody.pdp.commerceCard.promotion.promotions']}}
{{$productOrderCtrl.translations['antibody.pdp.commerceCard.promotion.viewpromo']}}
{{$productOrderCtrl.translations['antibody.pdp.commerceCard.promotion.promocode']}}: {{promo.promoCode}} {{promo.promoTitle}} {{promo.promoDescription}}. {{$productOrderCtrl.translations['antibody.pdp.commerceCard.promotion.learnmore']}}
图: 1 / 1
SLC10A2 Antibody (PA5-142400) in IHC (P)

产品信息
PA5-142400
种属反应
宿主/亚型
分类
类型
抗原
偶联物
形式
浓度
规格
纯化类型
保存液
内含物
保存条件
运输条件
RRID
产品详细信息
This antibody is tested in Peptide ELISA: antibody detection limit dilution 1:16,000.
靶标信息
This gene encodes a sodium/bile acid cotransporter. This transporter is the primary mechanism for uptake of intestinal bile acids by apical cells in the distal ileum. Bile acids are the catabolic product of cholesterol metabolism, so this protein is also critical for cholesterol homeostasis. Mutations in this gene cause primary bile acid malabsorption (PBAM); mutations in this gene may also be associated with other diseases of the liver and intestines, such as familial hypertriglyceridemia (FHTG).
仅用于科研。不用于诊断过程。未经明确授权不得转售。
篇参考文献 (0)
生物信息学
蛋白别名: Apical sodium-dependent bile acid transporter; ASBT; IBAT; ileal apical sodium-dependent bile acid transporter; ileal bile acid transporter; Ileal Na(+)/bile acid cotransporter; Ileal sodium-dependent bile acid transporter; Ileal sodium/bile acid cotransporter; Na(+)-dependent ileal bile acid transporter; Na+/taurocholate cotransporting polypeptide 2; Sodium/taurocholate cotransporting polypeptide, ileal; solute carrier family 10 (sodium/bile acid cotransporter family), member 2; solute carrier family 10 (sodium/bile acid cotransporter), member 2; Solute carrier family 10 member 2
基因别名: ASBT; IBAT; ISBT; NTCP2; PBAM; PBAM1; SLC10A2
UniProt ID: (Human) Q12908
Entrez Gene ID: (Human) 6555